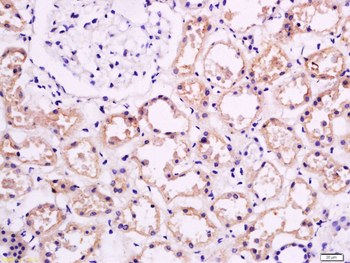
APOA1 Rabbit Polyclonal Antibody

You have no items in your shopping cart.
Description
Research Area
Images & Validation
−| Tested Applications | ELISA, IHC, IP, WB |
|---|---|
| Dilution Range | ELISA: 1:5,000 - 1:10,000, IHC: 1:250 - 1:500, IP: 1:100, WB: 1:500 - 1:1,000 |
| Reactivity | Mouse |
| Application Notes |
Key Properties
−| Antibody Type | Primary Antibody |
|---|---|
| Host | Goat |
| Clonality | Polyclonal |
| Isotype | IgG |
| Immunogen | apoLipoprotein Type A-I was isolated from mouse plasma by density gradient centrifugation followed by HPLC purification. |
| Target | Apoa1 |
| Purity | This product has been prepared by immunoaffinity chromatography using immobilized antigens followed by extensive cross-adsorption against other apoLipoproteins and human serum proteins to remove any unwanted specificities. Typically less than 1% cross-reactivity against other types of apoLipoprotein was detected by ELISA against purified standards. This antibody reacts with mouse apoLipoprotein A-I and has negligible cross-reactivity with Type A-II, B, C-I, C-II, C-III, E and J apoLipoproteins. Specific cross-reaction of anti-apoLipoprotein antibodies with antigens from other species has not been determined. Non-specific cross-reaction of anti-apoLipoprotein antibodies with other mouse serum proteins is negligible. |
| Conjugation | Unconjugated |
Storage & Handling
−| Storage | Store vial at 4° C prior to opening. This product is stable at 4° C as an undiluted liquid. Dilute only prior to immediate use. For extended storage, mix with an equal volume of glycerol, aliquot contents and freeze at -20° C or below. Avoid cycles of freezing and thawing. |
|---|---|
| Form/Appearance | Liquid (sterile filtered) |
| Buffer/Preservatives | Preservative: 0.01% (w/v) Sodium Azide. Stabilizer: None; Buffer: 0.125 M Sodium Borate, 0.075 M Sodium Chloride, 0.005 M EDTA, pH 8.0 |
| Concentration | 1.0 mg/mL |
| Expiration Date | 12 months from date of receipt. |
| Disclaimer | For research use only |
Alternative Names
−Similar Products
−APOA1 Rabbit Polyclonal Antibody [orb10643]
WB
Human
Mouse, Rat
Rabbit
Polyclonal
Unconjugated
50 μl, 100 μl, 200 μlApolipoprotein A I/APOA1 Rabbit Polyclonal Antibody [orb371650]
FC, ICC, IHC, WB
Human
Rabbit
Polyclonal
Unconjugated
100 μgAPOA1 Antibody [orb3161770]
ELISA, ICC, WB
Human, Mouse, Rat
Rabbit
Polyclonal
Unconjugated
50 μl, 100 μlAPOA1 Antibody [orb3161771]
ELISA, IF, IHC, WB
Human, Mouse, Rat
Rabbit
Polyclonal
Unconjugated
50 μl, 100 μl

Quality Guarantee
Explore bioreagents carefree to elevate your research. All our products are rigorously tested for performance. If a product does not perform as described on its datasheet, our scientific support team will provide expert troubleshooting, a prompt replacement, or a refund. For full details, please see our Terms & Conditions and Buying Guide. Contact us at support@biorbyt.com.

Immunofluorescence of Anti-Apolipoprotein AI. HDL isolated from AgNO3-injected mice colocalizes with biglycan at the cell surface of peritoneal macrophages. HDL from PBS- and AgNO3-injected C57BL/6 mice was isolated. After exposure to these HDL preparations (50 µg protein/mL) for 6 hours, TG-elicited peritoneal macrophages from Saa3–/– were fixed in 2% formalin for 5 minutes (A and B). After extensive washing, (A) APOA1 and biglycan were stained using anti-biglycan (red) and anti-APOA1 (green) antibodies, or (B) SAA and biglycan were stained using anti-biglycan (red) and ant-SAA (green) antibodies and photographed by fluorescence microscopy (Nikon Eclipse 80i, original magnification, ×200).

Immunofluorescence of Anti-Apolipoprotein AI. Versican colocalizes with HDL isolated from AgNO3-injected mice at the cell surface of 3T3-L1 adipocytes. Free SAA and HDL from PBS- or AgNO3-injected C57BL/6 mice were isolated. Some adipocytes were transfected with siRNA specific for versican (Vcan) for 3 days. After exposure to free SAA (15 µg/ml) and/or these HDL preparations (50 µg protein/mL) for 6 hours, 3T3-L1 adipocytes were fixed in 2% formalin for 5 minutes. After extensively washing, (A) APOA1 and versican were stained using anti-versican (shown in red) and anti-APOA1 (shown in green) antibodies, or (B) SAA and versican were stained using anti-versican (shown in red) and anti-SAA (shown in green) antibodies and photographed by fluorescence microscopy (Nikon Eclipse 80i, original magnification, ×200). Cell nuclei were counterstained with DAPI (blue). Cell morphology was shown by phase-contrast photography (left). Merged fluorescence (overlay) is shown in yellow.

Immunohistochemistry of Anti-Apolipoprotein AI. Immunohistochemical staining of versican and biglycan shows a similar distribution with the staining of SAA and APOA1 in the epididymal white adipose tissue from mice fed an HFHS diet and in the omental fat tissue from human obese subjects undergoing gastric bypass surgery. (A) Mice were fed a chow or HFHS diet for 16 weeks, after which adipose tissue was obtained and immunostained with the antibodies shown. Tissues were photographed using microscopy (original magnification, ×60). Quantitation of the immunostaining is shown in the lower panel (n = 5–7, mean ± SEM). *P < 0.001 vs. chow. (B) Omental fat was obtained from gastric bypass patients and immunostained with the antibodies shown. Tissues were photographed using microscopy (original magnification, ×60). The pictures of MAC2, CD68, versican, and biglycan staining are from our previous publication (17); APOA1 and SAA staining were performed on adjacent sections.

Western Blot of Anti-Apolipoprotein AI. Cholesterol transfer between nascent LpA-I (apo AI [apolipoprotein AI] containing particles formed by incubating ABCA1 [ATP-binding cassette transporter 1]-expressing cells with apo AI) and HDL3 takes place during particle remodeling in vitro. Cy5.5-LpA-I/TopFluor particles containing TopFluor-cholesterol were incubated with B-HDL3 (biotinylated HDL3) for 1 h at 37°C, final concentration of each lipoprotein was 0.5 mg/ml. Following treatment of the reaction mixtures with Sepharose beads (−) or Streptavidin Sepharose beads (+), lipoproteins remained in the supernatants were separated by nondenaturing polyacrylamide gradient gel electrophoresis. apo AI (A) and biotinylated apo AI (D) were detected with anti-apo AI antibody and NeutrAvidin, respectively. Cy5.5–apo AI (B) and TopFluor-cholesterol (C) were visualized by fluorescent imaging. The position of migration of lipid-poor apo AI is indicated. HDL, high-density lipoprotein.

Western Blot of Anti-Apolipoprotein AI. Lipoprotein particle remodeling is induced by the interaction of nascent LpA-I (apo AI [apolipoprotein AI] containing particles formed by incubating ABCA1 [ATP-binding cassette transporter 1]-expressing cells with apo AI) and HDL3 in vitro. Fluorescently labeled LpA-I (Cy5.5-LpA-I) and HDL3 (DL488-HDL3) were incubated for 1 h at 37°C, final concentration of each lipoprotein was 0.5 mg/ml. Lipoproteins were subjected to nondenaturing polyacrylamide gradient gel electrophoresis. Cy5.5–apo AI (left) and DL488–apo AI (middle) were visualized by fluorescent imaging, apo AI (right) was detected by anti-apo AI antibody. The migration of lipid-poor apo AI is also indicated. HDL indicates high-density lipoprotein.

Western Blot of Anti-Apolipoprotein AI. Phospholipid:protein ratio and lipid composition of discoidal HDLs (high-density lipoproteins) impact on interaction with HDL3 and apo AI (apolipoprotein AI) release. HDL3 (final protein concentration 1 mg/ml) was incubated for 1 h with different formulations of reconstituted HDL (final protein concentration 1 mg/ml) as indicated. Lipid-poor apo AI was analyzed either by Western blotting with anti–apo AI antibody following separation of lipoproteins by nondenaturing polyacrylamide gradient gel electrophoresis (A and C) or by pre-β1 HDL ELISA (B and D). Lipoproteins incubated alone in PBS were included as controls. A and B, Incubation at 37°C. C, Incubation at 17°C and 50°C. D, Shown data for incubations of HDL3 with phosphatidylcholine (PC) 100:1 apo AI (gray bars) and sphingomyelin (SM) 100:1 apo AI (white bars) at 17°C, 37°C and 50°C. B and D, Data from three independent experiments are shown. Values are presented as mean±SD. B, Pre-β1: ****P < 0.0001, ***P < 0.001, **P < 0.01, *P < 0.05 vs HDL3. D, Pre-β1: ####P < 0.0001 and *P < 0.05 vs HDL3, for incubations at 50°C and 37°C, respectively.

Western Blot of Anti-Apolipoprotein AI. Proteomics confirmation and hepatic gene expression. A: HDL preparations from the indicated treatment groups were subjected to immunoblot and probed for Saa (marker = 15 kD) and Apoa1 (marker = 35 kD). Densitometry was performed using ImageJ software. Control HDL samples were pooled; n = 3 for treatment groups. Different letters indicate significant differences, assessed using one-way ANOVA with multiple comparisons (Tukey) (P < 0.05). cH, control HDL from mice injected with saline; CR-HDL, HDL from mice fed an HFHS diet that were calorically restricted; 10, 12-HDL, HDL from mice fed an HFHS diet containing 10, 12 CLA; HFHS-HDL, HDL from mice fed an HFHS diet; sH, HDL from mice injected with silver nitrate. B: Liver gene expression was quantified from the indicated treatment groups. n = 8 mice/group, ∗P < 0.05 from HFHS.

Western Blot of Anti-Apolipoprotein AI. Small discoidal CSL112 induces more lipid-poor apo AI (apolipoprotein AI) upon incubation with HDL (high-density lipoprotein) compared with the nascent LpA-I (apo AI containing particles formed by incubating ABCA1 [ATP-binding cassette transporter 1]-expressing cells with apo AI). HDL3 or HDL2 (final protein concentration 1 mg/ml) were incubated for 1 h at 37°C in the absence or presence of increasing concentrations of LpA-I or CSL112 (at 0.05, 0.1, 0.2, and 0.4 mg protein/mL). Cholesterol efflux from RAW264.7 macrophages is shown (A and B). Final concentrations of LpA-I (A) or CSL112 (B) in efflux medium were 0.5, 1, 2, and 4 µg protein/mL; HDL3 or HDL2 were at 10 µg protein/mL, as indicated. Data from three independent experiments are shown. Values are presented as mean±SD. ABCA1-dependent efflux: ***P < 0.001, **P < 0.01 vs HDL2; ### P < 0.001 vs HDL3. C, HDL2 or HDL3 (final protein concentration 1 mg/ml) were incubated with LpA-I (0.2 and 0.4 mg/ml final protein concentrations; [LpA_0.2] and [LpA_0.4], respectively) or CSL112 (final protein concentration 0.2 mg/ml; [CSL112_0.2]) for 1 h at 37°C. Lipoproteins were separated by nondenaturing polyacrylamide gradient gel electrophoresis, and apo AI was detected by anti–apo AI antibody. The migration of lipid-poor apo AI is indicated.
Quick Database Links
UniProt Details
−NCBI Reference Sequences
−| Protein | NP_033822.2 |
|---|
Documents Download
Request a Document
Protocol Information
Apoa1 Antibody (orb345281)
Participating in our Biorbyt product reviews program enables you to support fellow scientists by sharing your firsthand experience with our products.
Login to Submit a Review